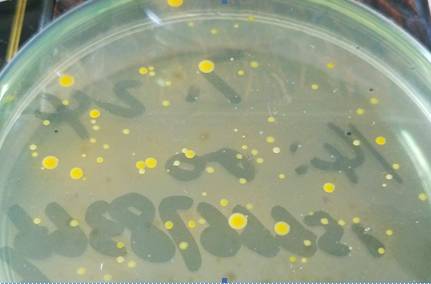

莆田洪老板,工厂化养殖南美白对虾,水泥池5×5米30个,每池放苗1.3万,体长6cm,ph8.5 氨氮1.0,亚硝酸盐0.2
养殖问题:
水中杂质较多,个别池子底脏。这边都是定期进行弧菌检测,水源弧菌指标正常,但经常有池子经检测弧菌超标,虾保持吃料正常。
.jpg)
解决方案:
1.外泼弧菌清0.5ppm+浓缩EM6源液4ppm,连用两次 2. 同时内服酵母金维(每包40斤料)三天,每天两次,用后检测弧菌控制在正常范围内,水体颜色也有所好转。
案例分析:
近段时间弧菌肆虐,从水源到池塘,不论绿弧菌还是黄弧菌超标严重,要想控制好,不让弧菌发病,还是从预防的角度入手,特别是高盐度海水养殖,
更是做好预防工作。
